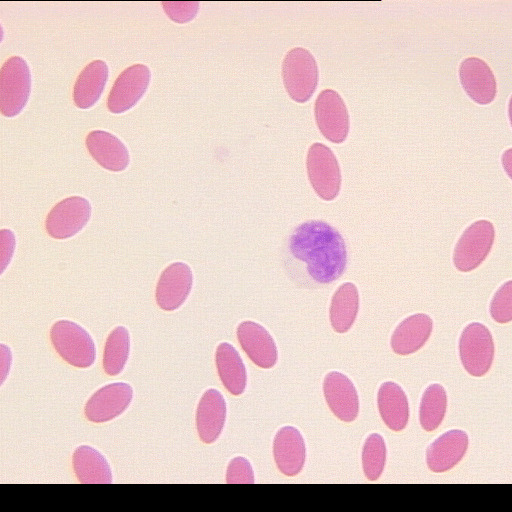
b5-8t45a.gif

Browse Items (6 total)
- Tags: Species (EN) / Espèces (FR) : Camelus sp.
Sort by:
Camelus sp.
Kingdom (EN) / Règne (FR) : Animalia / Animaux
Camelus sp.
Kingdom (EN) / Règne (FR) : Animalia / Animaux
Camelus sp.
Kingdom (EN) / Règne (FR) : Animalia / Animaux
Camelus sp.
Kingdom (EN) / Règne (FR) : Animalia / Animaux
Camelus sp.
Kingdom (EN) / Règne (FR) : Animalia / Animaux
Camelus sp.
Kingdom (EN) / Règne (FR) : Animalia / Animaux